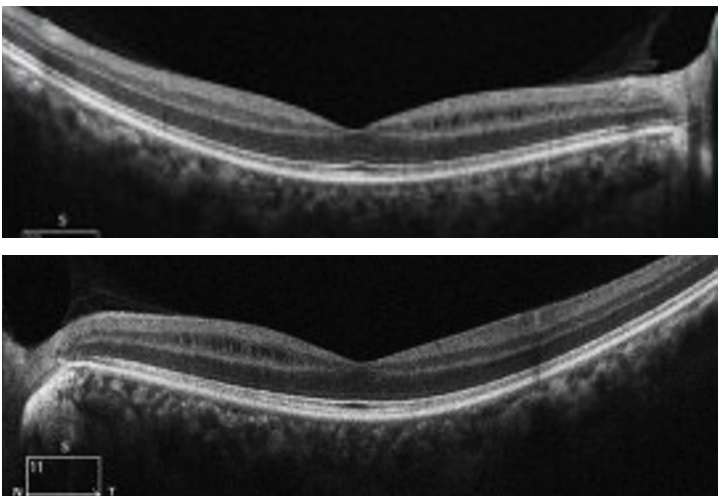

Thank you for the VF and OCT HIS VF ARE UNRELIABLE AND EYE TRACKER CONFIRMS THAT I WOULD RELY ON OCT AND IT APPEARS As AN OPTIC NEUROPATHY. These are not small pure central scotomas Try a 10-2 with a stern technician. Could be early glaucoma Doubt cialis but keep searching
Original Message:
Sent: 8/6/2025 6:37:00 PM
From: Yan Yan
Subject: RE: Cialis-Associated Optic Neuropathy?
Thanks for all the replies.
Folate 2.57ng/ml(Reference values > 4ng/ml), methylmalonic acid 19.56 ng/ml (<47.2 ng/ml), Vitamin B12 was not tested because there is no such test in the local hospital, but the malonic acid level is normal.
Macular line scan showed symmetrical MME, and that' s why I suspect he had optic neuropathy. THe outer retina looks normal.
FAF and FFA were all normal. ffERG was normal. mfERG was not performed.
The RNFL and GCA of Zeiss OCT and Humphrey VF were uploaded. I'm not sure if you can see it.
For HVF parameters: OD fixation loss 9/14, False POS 30%, False NEG 10%, Fovea 14dB, OS Fixation loss 4/14, False POS 14%, False NEG 3%, Fovea 33dB
------------------------------
Yan
------------------------------
Original Message:
Sent: 08-04-2025 07:24
From: Jeffrey Odel
Subject: Cialis-Associated Optic Neuropathy?
Hi Yan Yan:
What type of perimetry was used and what was his reliability? What was the foveal sensitivity. Echoing Matt Kay did he have exploration of cecocentral region with a tangent screen exam. Can you upload the fields? If this was a robust central defect unconnected to the blind spot in a reliable field it is virtually always retinal. Occult macular dystrophy comes to mind, if you do a 103 mfERG you will find delays if not decreased amplitude in the central stimulus. Occult macular dystrophy usually can be found on the genetic testing, but sometimes not.
Can you post the OCT of the fovea and autofluorescence.
Original Message:
Sent: 8/3/2025 1:16:00 AM
From: Yan Yan
Subject: RE: Cialis-Associated Optic Neuropathy?
He had bilateral small central scotoma.
He first noticed decreased vision when getting glasses 3 years ago, and his vision has been declining gradually, but it has improved a little this year, especially for the right eye, from the worst 20/40 to 20/30. He smokes one pack of cigarettes every day. He doesn't drink alcohol and takes no other recreational drugs. No toxic exposure or any cause for nutritional diseases. He has regular meals and exercises regularly. He only took medicine for the flu or COVID-19 medications when he was sick. During the period when he noticed his vision declining, he developed anxiety due to heavy work pressure, but he did not take any psychiatric medications and improved through exercises like running.
In addition, he was found to have ocular hypertension at that time, with an IOP of 25 mmHg, and he never had eyedrops for it. This year, he started using brimonidine, and his intraocular pressure has been kept below 20 mmHg.
------------------------------
Yan
Original Message:
Sent: 08-02-2025 20:35
From: Andrew Carey
Subject: Cialis-Associated Optic Neuropathy?
Doubt related to PDE5 inhibitor.
How large are the scotomas?
Did he have prior toxic exposure or cause for vitamin deficiency when vision loss started?
Most smokers drink alcohol. Did he previously drink alcohol or take disulfiram to encourage abstinence?
Best,
Drew
------------------------------
Andrew Carey
Associate Professor
Wilmer Eye Institute, Johns Hopkins Medicine
Baltimore MD
Original Message:
Sent: 08-02-2025 19:18
From: Yan Yan
Subject: Cialis-Associated Optic Neuropathy?
Dear All,
I have a case and would like to get your opinions.
This is a 45-year-old male patient. He experienced gradual decreased vision for 3 years, and retinal specialists diagnosed him with retinoschisis. He was referred to me for a second opinion. The examination revealed symmetrical papillomacular bundle atrophy and MME. Whole-exome and mitochondrial gene sequencing was performed, and the result was negative. Vitamin levels are normal. There is no family history. He smokes and does not drink alcohol. The visual acuity is 20/30 OD and 20/25 OS, respectively, with bilateral central scotomas, which is highly consistent with hereditary, metabolic or toxic optic neuropathy.
He has a special medication history: he started taking Cialis 9 years ago, once a week for the first four years, then 4-5 times a year thereafter, and from January to May this year, once every 3 days. He did not take excessive doses. There has been no significant progression in the recent six months. His examination findings are inconsistent with AION; there is no acute visual loss.
Does anyone have patients with metabolic or toxic optic neuropathy caused by Cialis?
Best,
------------------------------
Yan
------------------------------